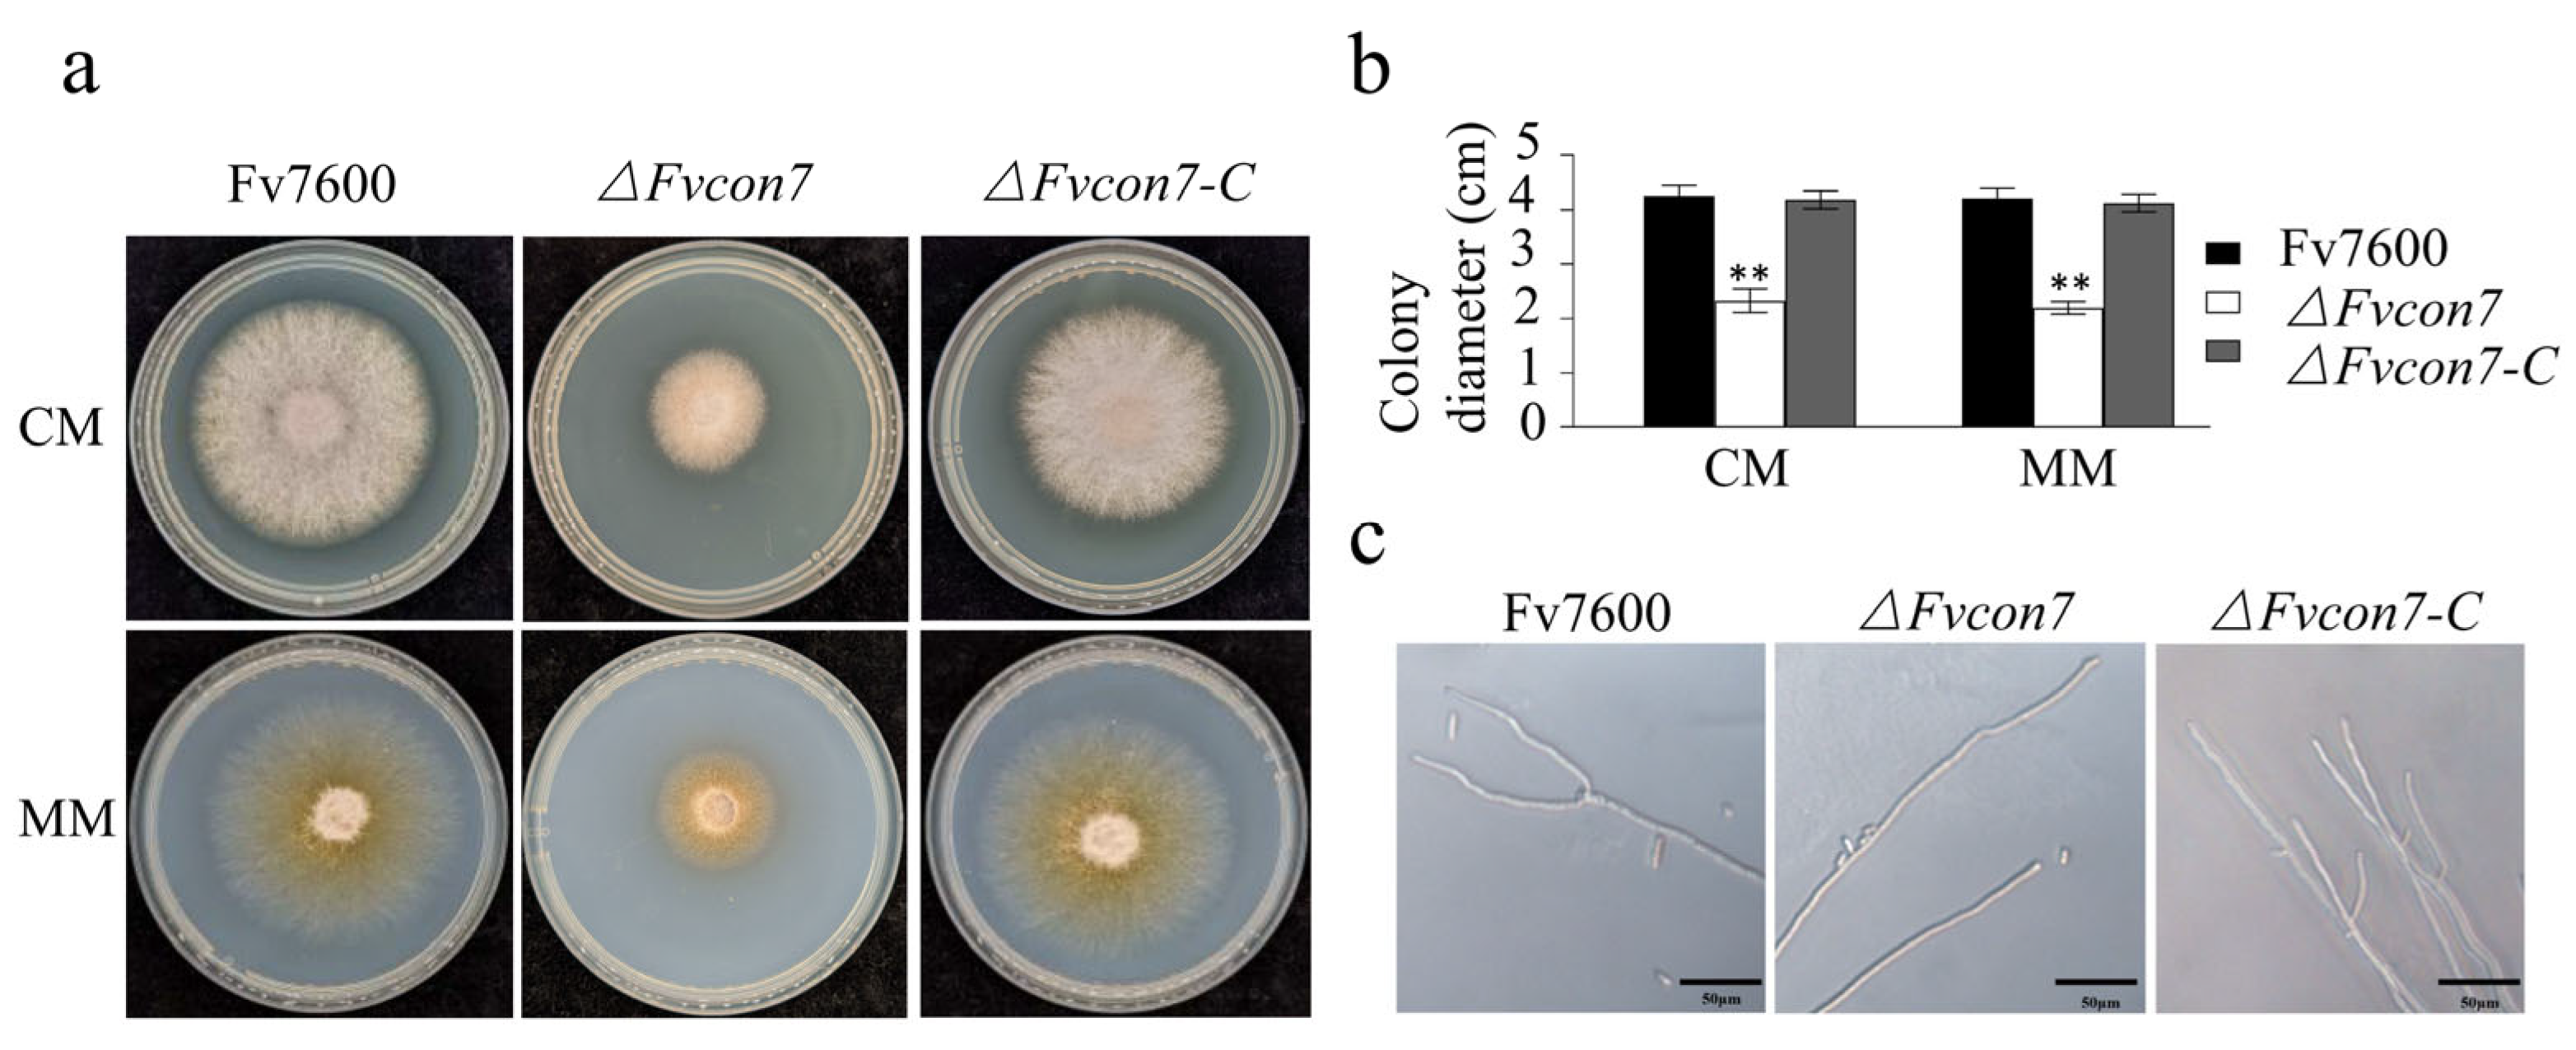
Plants 14 02725 g001

The Global Transcription Factor FvCon7 Plays a Role in the Morphology, FB1 Toxin Production, and Pathogenesis of Fusarium verticillioides
Abstract
1. Introduction
2. Results
2.1. Identification of the C2H2 Zinc Finger Transcription Factor FvCon7 in F. verticillioides
2.2. FvCon7 Contributes to a Variety of Morphological Defects in Vegetative Growth and Conidia Development
2.2.1. Generation of ΔFvcon7, ΔFvcon7-C, and FvCON7:GFP
2.2.2. FvCon7 Is Essential for Vegetative Growth
2.2.3. FvCon7 Is Essential for Conidia Genesis
2.3. FvCon7 Is Involved in Cell Wall Structure and the Regulation of Different Stresses
2.4. Fvcon7 Is Involved in Carbon Metabolism Regulation
2.5. Fvcon7 Is a Transcription Factor of FB1
2.6. FvCon7 Contributes to Virulence
2.7. FvCon 7 Plays an Important Role in Multiple Metabolic Pathways
3. Discussion
4. Materials and Methods
4.1. Bioinformatics Analysis
4.2. Strain and Growth Conditions
4.3. Electron Microscope Observation
4.4. Yeast Two-Hybrid (Y2H) Assay and Yeast One-Hybrid (Y1H) Assay
4.5. Determination of Pathogenicity and Fumonisin FB1 Production
4.6. RNA Sequencing and Fluorescent Real-Time Quantitative PCR (qRT-PCR) Analysis
Author Contributions
Funding
Data Availability Statement
Conflicts of Interest
Appendix A




Appendix B
| Name | Sequence (5′→3′) | Experimental Use |
|---|---|---|
| FvCon7-AF | ATTTCTTGCCTGTGAGCC | Gene knock-out |
| FvCon7-AR | TTGACCTCCACTAGCTCCAGCCAAGCCGCAGTAGTAGCGCCGTTT | |
| FvCon7-BF | GAATAGAGTAGATGCCGACCGCGGGTTAAGCCACTAAGACGGATGG | |
| FvCon7-BR | CTTGTGACCCGACAGACC | |
| FvCon7-ORFF | GGCGTCTATCCTCAGTCAGC | |
| FvCon7-ORFR | CCGAGGTCGTTTATGCTGTT | |
| FvCon7-UA | GGGACTCGTCGGTAGAAC | |
| YG/F | GATGTAGGAGGGCGTGGATATGTCCT | |
| HY/R | GTATTGACCGATTCCTTGCGGTCCGAA | |
| HYG/F | GGCTTGGCTGGAGCTAGTGGAGGTCAA | |
| HYG/R | AACCCGCGGTCGGCATCTACTCTATTC | |
| H853 | GACAGACGTCGCGGTGAGTT | |
| FvCon7-PF | GGGTACCGGGCCCCCCCTCGAGTTGTCCTCTGAGTGGACCTT | |
| FvCon7-OR GFP | TCCTCGCCCTTGCTCACCAT AGTCACCCTCTGCCTCTGCG | |
| GFPF | ATGGTGAGCAAGGGCGAGGA | |
| GFPR | CGACCTGCAGGCATGCAAGCTTTTACTTGTACAGCTCGTCCATGC | |
| FvCon7-ADF | GACGTACCAGATTACGCTCAT ATGTCTCTGGTGCCAACACAG | Yeast-two-hybrid assay |
| FvCon7-ADR | TATCGATGCCCACCCGGGTGGAATTAGTGGCTTGGGGGTTGAC | |
| FvCon7-BDF | CTGATCTCAGAGGAGGACCTGCATATGTCTCTGGTGCCAACACAG | |
| FvCon7-BDR | CGCTGCAGGTCGACGGATCCCCGGGAATTAGTGGCTTGGGGGTTGAC | |
| FvFUM3-ProF | AAGCTTGAATTCGAGCTTCATTCCATAAACCTCCAAT | Yeast-one-hybrid assay |
| FvFUM3-ProR | CCTCGAGGTCGACAGATCCCCGCAGGATTGCCAAGATTACT | |
| FvFUM3-ProF1 | AAGCTTGAATTCGAGCTCATGCGTGAGGGTATCCATT | |
| FvFUM3-ProR1 | CCTCGAGGTCGACAGATCCCCGATAAGCAAACTCAACGTTT | |
| FvFUM10-ProF | AAGCTTGAATTCGAGCTGTATTTAGATTCCGTTATAT | |
| FvFUM10-ProR | CCTCGAGGTCGACAGATCCCCCTCTGAATTGGCTTTACATC | |
| FvFUM15-ProF | AAGCTTGAATTCGAGCTGGTGTTTGACTAGCCGAGCT | |
| FvFUM15-ProR | CCTCGAGGTCGACAGATCCCCAAGGCTTTGAGCAAGGTCAA | |
| FvFUM15-ProF1 | AAGCTTGAATTCGAGCTATAGGGTATGTAGCCACAAC | |
| FvFUM15-ProR1 | CCTCGAGGTCGACAGATCCCCAAGTAACTTGCAACCGATGC | |
| FvFUM17-ProF | AAGCTTGAATTCGAGCTGCTAGAGAGGCCCAACTTGC | |
| FvFUM17-ProR | CCTCGAGGTCGACAGATCCCCGCGCTAAATTGTACCCTGAT | |
| FvFUM16-ProF | AAGCTTGAATTCGAGCTAGAAAGCTGGTGTCTGGAGG | |
| FvFUM16-ProR | CCTCGAGGTCGACAGATCCCCCCTCAGCTACCGGTTTCATT | |
| FvFUM16-ProF1 | AAGCTTGAATTCGAGCTTAAATCCAGGCAATGACACA | |
| FvFUM16-ProR1 | CCTCGAGGTCGACAGATCCCCACATTATCACCATTACACTC | |
| FvActin-QF | GTCTGGATCGGTGGTTCTATTC | RT-qPCR |
| FvActin-QR | ACTTGCGGTGAACGATTGA | |
| FvFum1-QF | GCTCTAGAGAACCGCACTATTC | |
| FvFum1-QR | TCAACTGGTACCGCCATATTC | |
| FvFum8-QF | ATCACCGCCACTGTCTTTAC | |
| FvFum8-QR | GAAGCGTCGGACTTGATACTT | |
| FvFum19-QF | CATCACACGAGCACCACTATAC | |
| FvFum19-QR | GCTGACGAGATGTCCGTAAATAG | |
| FvFum21-QF | TTGCGAGGATCTGTTCTTCTATC | |
| FvFum21-QR | TATTACCGAGCTTGCGCTATAC | |
| FvflbB-QF | GATGGCGATACGAACCAGAA | |
| FvflbB-QR | CCCAAGACATGATAGGAGTTACC | |
| FvfluG-QF | GGGTAGTCATTGGGAGATCAAG | |
| FvfluG-QR | GCCCTTTGTACCCGCTAATA | |
| FvstuA-QR | TCGAAGTTGCCTGCAGAAT | |
| FvflbC-QF | GGTATGTTGGCTATGAGTCAGG | |
| FvflbC-QR | GTCGAATGGGTAGAAGGGAATC | |
| FvChs1-QF | CTCGGATGGGGTGAACCTG | |
| FvChs1-QR | GAAACCGGCAAAACGAACGA | |
| FvChs6-QF | CCCAACGATCGACGAATTGC | |
| FvChs6-QR | CAAAAACTCGCCGAAAGGCA | |
| FvChs7-QF | AGCTAGGAAGCGGTACCAGA | |
| FvChs7-QR | CCAGGGACCGATATGTCTGC | |
| FvPkcA-QF | TCACAATTCCCCATGAGCCC | |
| FvPkcA-QR | GGACCGGTCTCTGTTCCTTG | |
| FvFksA-QF | AATTGTCCTGGCCCTGATGG | |
| FvFksA-QR | GTTACGCCAAGGTGTCCAGA | |
| FvCon7-t1-F | ATGTCTCTGGTGCCAACACA | Transcript identification |
| FvCon7-t1-R | TTAGTGGCTTGGGGGTTG | |
| FvCon7-t2-R | CTAAGTCACCCTCTGCCTCTG | |
| FvCon7-t3-R | TTAGGCATCTGTGCTCATC | |
| FvCon7-t4-F | GTGCTACGGAGTACTCGC | |
| FvCon7-t4-R | CGAAGCGTAAGTTGGGCT | |
| FvCon7-t5-F | ATCTGCTGCGCAATATCCT |
References
- Marasas, W.F.O.; Riley, R.T.; Hendricks, K.A.; Stevens, V.L.; Sadler, T.W.; Gelineau-van, W.J. Fumonisins disrupt sphingolipid metabolism, folate transport, and neural tube development in embryo culture and in vivo: A potential risk factor for human neural tube defects among populations consuming fumonisin- contaminated maize. J. Nutr. 2004, 134, 711–716. [Google Scholar] [CrossRef] [PubMed]
- Marasas, W.F.O.; Kellerman, T.S.; Gelderblom, W.C.A.; Coetzer, J.A.W.; Thiel, P.G.; van der Lugt, J.J. Leukoence-phalomalacia in a horse induced by fumonisin B1 isolated from Fusarium moniliforme. Onderstepoort J. Vet. Res. 1988, 55, 197–203. [Google Scholar] [PubMed]
- Shi, Z.; Leung, H. Genetic analysis of sporulation in Magnaporthe grisea by chemical and insertional mutagenesis. Mol. Plant Microbe Interact. 1995, 8, 949–959. [Google Scholar] [CrossRef]
- Shin, S.; Park, J.; Yang, L.; Kim, H.; Choi, G.J.; Lee, Y.W.; Kim, J.E.; Son, H. Con7 is a key transcription regulator for conidiogenesis in the plant pathogenic fungus Fusarium graminearum. Msphere 2024, 9, e00818-23. [Google Scholar] [CrossRef]
- Zhou, S.; Liu, S.; Guo, C.; Wei, H.; He, Z.; Liu, Z.; Li, X. The C2H2 transcription factor Con7 regulates vegetative growth, cell wall integrity, oxidative stress, asexual sporulation, appressorium and hyphopodium formation, and pathogenicity in Colletotrichum graminicola and Colletotrichum siamense. J. Fungi 2024, 10, 495. [Google Scholar] [CrossRef]
- Odenbach, D.; Breth, B.; Thines, E.; Weber, R.W.S.; Anke, H.; Foster, A.J. The transcription factor Con7p is a central regulator of infection-related morphogenesis in the rice blast fungus Magnaporthe grisea. Mol. Microbiol. 2007, 64, 293–307. [Google Scholar] [CrossRef]
- Fan, G.; Zheng, H.; Zhang, K.; Devi Ganeshan, V.; Opiyo, S.O.; Liu, D.; Li, M.; Li, G.; Mitchell, T.K.; Yun, Y.; et al. FgHtf1 Regulates Global Gene Expression towards Aerial Mycelium and Conidiophore Formation in the Cereal Fungal Pathogen Fusarium graminearum. Appl. Environ. Microbiol. 2020, 86, e03024-19. [Google Scholar] [CrossRef]
- Chen, S.; Li, P.; Abubakar, Y.S.; Lü, P.; Li, Y.; Mao, X.; Zhang, C.; Zheng, W.; Wang, Z.; Lu, G.D.; et al. A feedback regulation of FgHtf1-FgCon7 loop in conidiogenesis and development of Fusarium graminearum. Int. J. Biol. Macromol. 2024, 261 Pt 2, 129841. [Google Scholar] [CrossRef]
- Odenbach, D.; Thines, E.; Anke, H.; Foster, A.J. The Magnaporthe grisea class VII chitin synthase is required for normal appressorial development and function. Mol. Plant Pathol. 2009, 10, 81–94. [Google Scholar] [CrossRef]
- Shi, Z.; Christian, D.; Leung, H. Interactions between spore morphogenetic mutations affect cell types, sporulation, and pathogenesis in Magnaporthe grisea. Mol. Plant Microbe Interact. 1998, 11, 199–207. [Google Scholar] [CrossRef]
- Yang, J.; Kong, L.; Ding, S.; Zhao, X.; Zhao, W.; Peng, Y. A study on two nuclear proteins involved in appressorium formation by Magnaporthe oryzae. Ann. Achi. Acta Phytopathol. Soc. 2007, 121. [Google Scholar]
- Kong, L.A.; Li, G.T.; Liu, Y.; Liu, M.G.; Zhang, S.J.; Yang, J.; Zhou, X.Y.; Peng, Y.L.; Xu, J.R. Differences between appressoria formed by germ tubes and appressorium-like structures developed by hyphal tips in Magnaporthe oryzae. Fungal Genet. Biol. 2013, 56, 33–41. [Google Scholar] [CrossRef] [PubMed]
- Nakajima, Y.; Saitoh, K.; Arie, T.; Teraoka, T.; Kamakura, T. Expression specificity of CBP1 is regulated by transcriptional repression during vegetative growth of Magnaporthe oryzae. J. Gen. Appl. Microbiol. 2010, 56, 437–445. [Google Scholar] [CrossRef] [PubMed][Green Version]
- Kamakura, T.; Yamaguchi, S.; Saitoh, K.; Teraoka, T.; Yamaguchi, I. A novel gene, CBP1, encoding a putative extracellular chitin-binding protein, may play an important role in the hydrophobic surface sensing of Magnaporthe grisea during appressorium differentiation. Mol. Plant Microbe Interact. 2002, 15, 437–444. [Google Scholar] [CrossRef]
- Ruiz-Roldan, C.; Pareja-Jaime, Y.; Gonzalez-Reyes, J.A.; Roncero, M.I. The transcription factor Con7-1 is a master regulator of morphogenesis and virulence in Fusarium oxysporum. Mol. Plant Microbe Interact. 2015, 28, 55–68. [Google Scholar] [CrossRef]
- Tran, V.T.; Braus-Stromeyer, S.A.; Kusch, H.; Reusche, M.; Kaever, A.; Kuhn, A.; Valerius, O.; Landesfeind, M.; Asshauer, K.; Tech, M. Verticillium transcription activator of adhesion Vta2 suppresses microsclerotia formation and is required for systemic infection of plant roots. New Phytol. 2014, 202, 565–581. [Google Scholar] [CrossRef]
- Lin, S.Y.; Chooi, Y.H.; Solomon, P.S. The global regulator of pathogenesis PnCon7 positively regulates Tox3 effector gene expression through direct interaction in the wheat pathogen Parastagonospora nodorum. Mol. Microbiol. 2018, 109, 78–90. [Google Scholar] [CrossRef]
- Proctor, R.H.; Brown, D.W.; Plattner, R.D.; Desjardins, A.E. Co-expression of 15 contiguous genes delineates a fumonisin biosynthetic gene cluster in Gibberella moniliformis. Fungal Genet. Biol. 2003, 38, 237–249. [Google Scholar] [CrossRef]
- Seo, J.A.; Proctor, R.H.; Plattner, R.D. Characterization of four clustered and coregulated genes associated with fumonisin biosynthesis in Fusarium verticillioides. Fungal Genet. Biol. 2001, 34, 155–165. [Google Scholar] [CrossRef]
- Peng, M.; Wang, J.; Lu, X.; Wang, M.; Wu, C.; Lu, G.; Wang, Z.; Shim, W.B.; Yu, W. Functional analysis of cutinase transcription factors in Fusarium verticillioides. Phytopathol. Res. 2024, 6, 48. [Google Scholar] [CrossRef]
- Ye, J.; Zhang, Y.; Cui, H.; Liu, J.; Wu, Y.; Cheng, Y. WEGO 2.0: A web tool for analyzing and plotting GO annotations, 2018 update. Nucleic Acids. Res. 2018, 46, W71–W75. [Google Scholar] [CrossRef] [PubMed]
- Dennis, G., Jr.; Sherman, B.T.; Hosack, D.A.; Yang, J.; Gao, W.; Lane, H.C.; Lempicki, R.A. DAVID: Database for annotation, visualization, and integrated discovery. Genome Biol. 2003, 4, P3. [Google Scholar] [CrossRef]
- Syme, R.A.; Tan, K.C.; Hane, J.K.; Dodhia, K.; Stoll, T.; Hastie, M. Comprehensive annotation of the Parastagonospora nodorum reference genome using next-generation genomics, transcriptomics and proteogenomics. PLoS ONE 2016, 11, e0147221. [Google Scholar] [CrossRef] [PubMed]
- Li, Z.; Yang, J.; Peng, J.; Cheng, Z.; Liu, X.; Zhang, Z.; Bhadauria, V.; Zhao, W.; Peng, Y.L. Transcriptional landscapes of long non-coding RNAs and alternative splicing in Pyricularia oryzae revealed by RNA-Seq. Front. Plant Sci. 2021, 12, 723636. [Google Scholar] [CrossRef]
- Ram, A.F.; Kapteyn, J.C.; Montijn, R.C.; Caro, L.H.; Douwes, J.E.; Baginsky, W. Loss of the plasma membrane-bound protein Gas1p in Saccharomyces cerevisiae results in the release of β1,3-glucan into the medium and induces a compensation mechanismto ensure cell wall integrity. J. Bacteriol. 1998, 180, 1418–1424. [Google Scholar] [CrossRef]
- Verwer, P.E.; van Duijn, M.L.; Tavakol, M.; Bakker-Woudenberg, I.A.; van de Sande, W.W. Reshuffling of Aspergillus fumigatus cell wall components chitin and β-glucan under the influence of caspofungin or nikkomycin Z alone or in combination. Antimicrob. Agents Chemother. 2012, 56, 1595–1598. [Google Scholar] [CrossRef]
- Steidl, S.; Hynes, M.J.; Brakhage, A.A. The Aspergillus nidulans multimeric CCAAT binding complex AnCF is negatively autoregulated via its hapB subunit gene. J. Mol. Biol. 2001, 306, 643–653. [Google Scholar] [CrossRef]
- Weidner, G.; Steidl, S.; Brakhage, A.A. The Aspergillus nidulans homoaconitase gene lysF is negatively regulated by the multimeric CCAAT-binding complex AnCF and positively regulated by GATA sites. Arch. Microbiol. 2001, 175, 122–132. [Google Scholar] [CrossRef]
- Kumar, S.; Stecher, G.; Tamura, K. MEGA7: Molecular evolutionary genetics analysis version 7.0 for bigger datasets. Mol. Biol. Evol. 2016, 33, 1870–1874. [Google Scholar] [CrossRef]
- Lin, M.; Abubakar, Y.S.; Wei, L.; Wang, J.; Lu, X.; Lu, G.; Wang, Z.; Zhou, J.; Yu, W. Fusarium verticillioides Pex7/20 mediates peroxisomal PTS2 pathway import, pathogenicity and fumonisin B1 biosynthesis. Appl. Microbiol. Biotechnol. 2022, 106, 6595–6609. [Google Scholar] [CrossRef]
- Yu, W.; Wang, J.; Wang, M.; Wen, G.; Liang, J.; Chen, X.; Lu, G.; Wang, Z.; Huang, J. Regulation of fumonisin B1 production and pathogenicity in Fusarium verticillioides by histone deacetylases. Agronomy 2024, 14, 2196. [Google Scholar] [CrossRef]

Disclaimer/Publisher’s Note: The statements, opinions and data contained in all publications are solely those of the individual author(s) and contributor(s) and not of MDPI and/or the editor(s). MDPI and/or the editor(s) disclaim responsibility for any injury to people or property resulting from any ideas, methods, instructions or products referred to in the content. |
© 2025 by the authors. Licensee MDPI, Basel, Switzerland. This article is an open access article distributed under the terms and conditions of the Creative Commons Attribution (CC BY) license (https://creativecommons.org/licenses/by/4.0/).
Share and Cite
Wen, G.; Lu, X.; Liang, J.; Liu, Y.; Zhang, X.; Lu, G.; Wang, Z.; Yu, W. The Global Transcription Factor FvCon7 Plays a Role in the Morphology, FB1 Toxin Production, and Pathogenesis of Fusarium verticillioides. Plants 2025, 14, 2725. https://doi.org/10.3390/plants14172725
Wen G, Lu X, Liang J, Liu Y, Zhang X, Lu G, Wang Z, Yu W. The Global Transcription Factor FvCon7 Plays a Role in the Morphology, FB1 Toxin Production, and Pathogenesis of Fusarium verticillioides. Plants. 2025; 14(17):2725. https://doi.org/10.3390/plants14172725
Chicago/Turabian StyleWen, Gaolong, Xiange Lu, Jiayan Liang, Yi Liu, Xudong Zhang, Guodong Lu, Zonghua Wang, and Wenying Yu. 2025. "The Global Transcription Factor FvCon7 Plays a Role in the Morphology, FB1 Toxin Production, and Pathogenesis of Fusarium verticillioides" Plants 14, no. 17: 2725. https://doi.org/10.3390/plants14172725
APA StyleWen, G., Lu, X., Liang, J., Liu, Y., Zhang, X., Lu, G., Wang, Z., & Yu, W. (2025). The Global Transcription Factor FvCon7 Plays a Role in the Morphology, FB1 Toxin Production, and Pathogenesis of Fusarium verticillioides. Plants, 14(17), 2725. https://doi.org/10.3390/plants14172725

